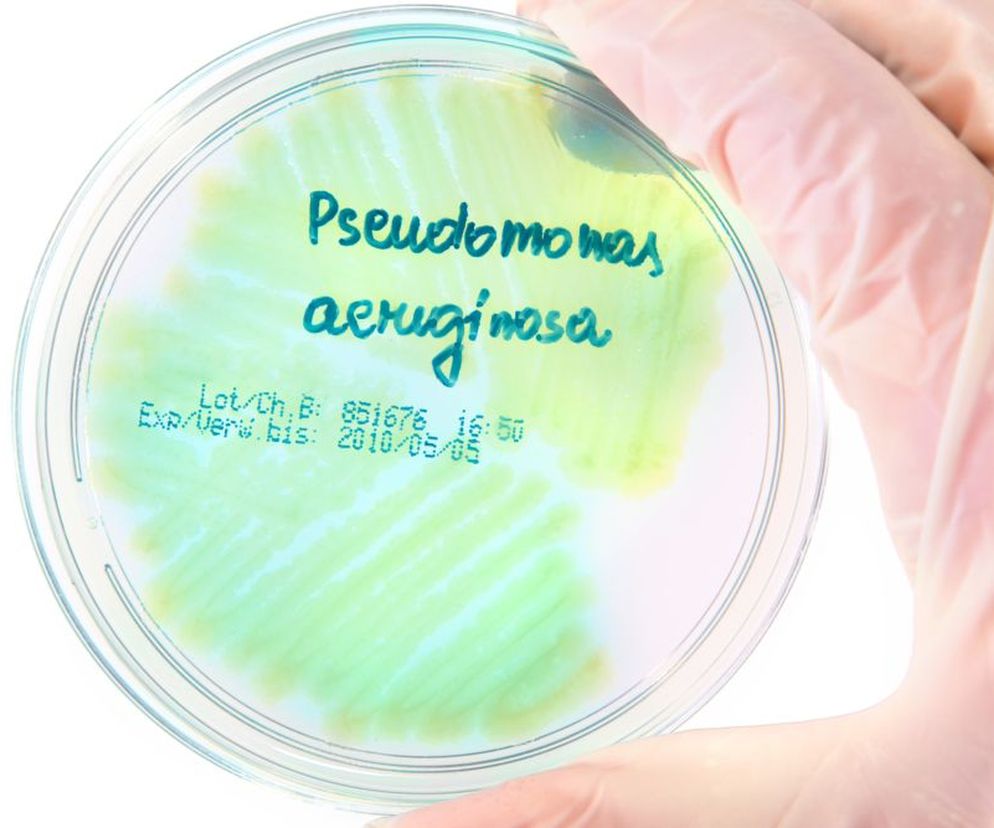
Pałeczka ropy błękitnej  to jedna z najniebezpieczniejszych bakterii

Pałeczka ropy błękitnej (Pseudomonas aeruginosa) to bakteria, która żyje głównie w wodzie i glebie, jednak może występować także na skórze człowieka i zwierząt. Jest ona niewrażliwa na stosowane powszechnie środki dezynfekcyjne, a także odporna na działanie większości antybiotyków, co znacznie utrudnia leczenie zakażeń przez nią powodowanych.
Pałeczka ropy błękitnej - jak można się zarazić?
Pałeczka ropy błękitnej należy do grupy bakterii oportunistycznych, tzn. takich, które wywołują zakażenie tylko u osób z obniżoną odpornością. W związku z tym na zakażenie najbardziej są narażone osoby, które zmagają się z chorobami krwi, AIDS lub chorują na mukowiscydozę, cukrzycę i nowotwory (a dodatkowo są w trakcie chemioterapii). Ryzyko zakażenia wzrasta także u osób zażywających narkotyki, które doznały oparzeń dużej powierzchni ciała lub rozległych urazów. Ponadto bakteria może dostać się do organizmu drogą zakażenia wewnątrzszpitalnego.
Pałeczka ropy błękitnej - jakie choroby wywołuje?
- infekcje skóry i tkanek miękkich - zwykle są ciężkimi powikłaniami oparzeń i powikłaniami pooperacyjnymi i zakażenia ran;
- zakażenie układu oddechowego - szczególne zagrożenie stanowi dla pacjentów z mukowiscydozą i przewlekle mechanicznie wentylowanych;
- zakażenie układu pokarmowego;
- zakażenia dróg moczowych (osoby cewnikowane);
- zapalenie ucha środkowego i zewnętrznego (tzw. ucho pływaka)
- zapalenie zatok;
- zakażenie oczu u pacjentów z soczewkami kontaktowymi (pałeczka ropy błękitnej jest jednym z najczęstszych patogenów wywołujących bakteryjne zapalenie rogówki);
- zakażenie ośrodkowego układu nerwowego;
- zapalenie opon mózgowo-rdzeniowych;
- zapalenie wsierdzia i osierdzia;
- zapalenie kości/szpiku kostnego/stawów;
Pałeczka ropy błękitnej - sepsa najpoważniejszym skutkiem zakażenia
Pałeczka ropy błękitnej jest niewrażliwa na stosowane powszechnie środki dezynfekcyjne, dodatkowo niewiele jej trzeba do przeżycia, łatwo rozprzestrzenia się w środowisku wodnym i jest odporna na antybiotyki. W związku z tym należy do najgroźniejszych i najczęstszych przyczyn zakażeń szpitalnych, w tym ciężkich i zagrażających życiu infekcji krwi (sepsa).
Pałeczka ropy błękitnej - leczenie
Stosuje się antybiotykoterapię. Niestety, leczenie zakażeń wywołanych pałeczką ropy błękitnej jest bardzo trudne, gdyż bakteria ta jest oporna na działanie większości antybiotyków.
Pałeczka ropy błękitnej - jak zapobiec zakażeniu?
W aptekach jest dostępna szczepionka przeciw pałeczce ropy błękitnej. Jak dowiadujemy się z ulotki, można ją stosować profilaktycznie, w celu uzyskania odporności na zakażenia wywołane przez pałeczkę ropy błękitnej, leczniczo w zakażeniach pałeczką ropy błękitnej oraz w stanach zagrożenia zakażeniem i posocznicą wywołaną przez pałeczkę ropy błękitnej u chorych z rozległymi oparzeniami powłok skórnych. Szczepionkę należy podawać zgodnie z zaleceniami lekarza.
Ponadto należy przestrzegać zasad higieny osobistej.